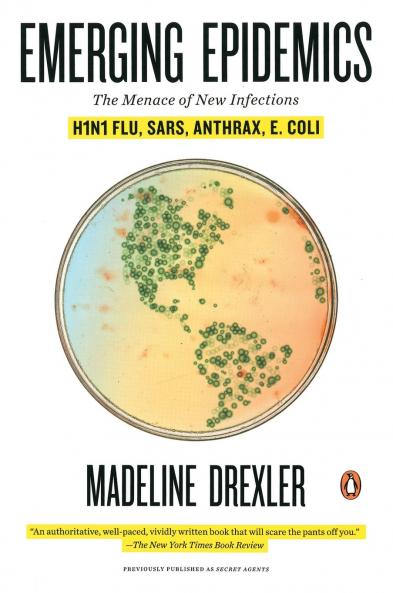
Emerging Epidemics

English
Paperback
₹1984
₹2593
23.49% OFF
(All inclusive*)
Delivery Options
Please enter pincode to check delivery time.
*COD & Shipping Charges may apply on certain items.
Review final details at checkout.
Looking to place a bulk order? SUBMIT DETAILS
About The Book
Description
Author
As timely as it is urgent the well-researched book from veteran science journalist Madeline Drexler delivers a compelling report about today's most ominous infections disease threats. Focusing on a different danger in each chapter-from the looming risk of lethal influenza to in-depth information on the public health perils posed by bioterrorism-Drexler takes readers straight to the front lines where scientists are racing to catch nearly invisible adversaries superior in speed and guile. Drawing on a powerful combination of fresh research and surprising history she warns us that the most ceaselessly creative bioterrorist is still Mother Nature whose microbial operatives are all around us ready to ounce whenever conditions are right.
Delivery Options
Please enter pincode to check delivery time.
*COD & Shipping Charges may apply on certain items.
Review final details at checkout.
Details
ISBN 13
9780143117179
Publication Date
-23-12-2009
Pages
-336
Weight
-360 grams
Dimensions
-135x203x17.8 mm